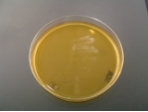
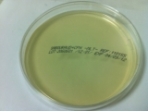
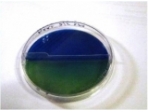

mikrobiologie labor technik distributie
- HOME
- PRODUSE
- Medii turnate in placi Petri - producator MLT
- Medii turnate in tuburi - producator MLT
- Medii turnate in sticle - producator MLT
- Medii deshidratate
- Suplimente pentru medii
- Reactivi si seruri latex pentru identificare microbiana
- Discuri antibiograma / antifungigrama
- Tulpini de referinta
- Sisteme biochimice de identificare si/sau antibiograma
- Teste rapide
- Coloratii
- Dip-Slide
- CONS-LAB - divizia de consumabile pentru laborator
- Reactivi imunologie, etc.
- Controale sterilizare
- Diverse
- COSUL MEU
- CUM CUMPAR
- DESPRE NOI
- CONTACT
CAUTARE


CATEGORII
- Medii turnate in placi Petri - producator MLT
- Medii turnate in tuburi - producator MLT
- Medii turnate in sticle - producator MLT
- Medii deshidratate
- Suplimente pentru medii
- Reactivi si seruri latex pentru identificare microbiana
- Discuri antibiograma / antifungigrama
- Tulpini de referinta
- Sisteme biochimice de identificare si/sau antibiograma
- Teste rapide
- Coloratii
- Dip-Slide
- CONS-LAB - divizia de consumabile pentru laborator
- Reactivi imunologie, etc.
- Controale sterilizare
- Diverse
CERTIFICATE
Pentru vizualizarea certificatelor de control, va rugam sa specificati codul produsului si lotul, informatii inscrise pe ambalajul produselor.
NEWSLETTER
ATENTIE - IMPORTANT !!!
Posibilitate - Pot exista produse destinate laboratorului de microbiologie (medii de cultura, accesorii, consumabile, etc.) pe care le cautati, dar pe care nu le gasiti pe site-ul nostru.
De ce? - Nu dorim incarcarea excesiva a site-ului MLT.
De ce nu? - Un site prea incarcat se deschide greu.
Sugestie - Produsele cautate de dumneavoastra ar putea fi disponibile la cerere.
Rezolvare - Va rugam sa ne contactati pentru a obtine informatiile dorite. CONTACT.
© Mikrobiologie Labor-Technik 2011 - 2026